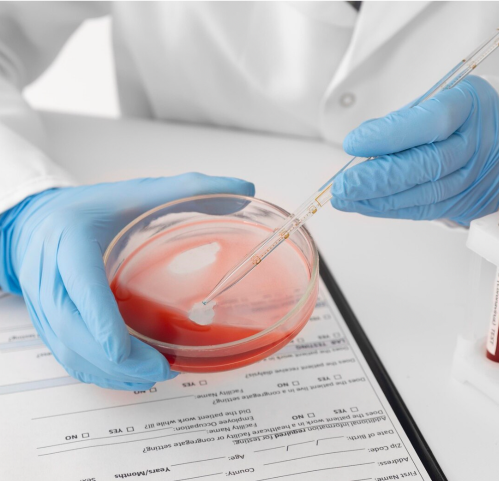

Ліпосакція стегон
Ліпосакція стегон — це вид естетичної хірургії. Основна мета — видалення жирових відкладень у цій зоні, а також на ногах, сідницях, надання тілу акуратних контурів. Операцію проводять за допомогою лазера, що робить її менш травматичною. Можна позбутися жиру в проблемних зонах без наслідків для організму. У клініці «Авіцена» в Черкасах хірурги надають допомогу тим, хто хоче повернути тілу красиві форми й обриси.
52208 грн
52208 грн
Наша команда
64636 ГРН
64636 ГРН
39780 ГРН
39780 ГРН
45760 ГРН
45760 ГРН
39780 ГРН
39780 ГРН
24856 ГРН
24856 ГРН
149188 ГРН
149188 ГРН
69628 ГРН
69628 ГРН
43004 ГРН
43004 ГРН
45760 ГРН
45760 ГРН
49712 ГРН
49712 ГРН
39780 ГРН
39780 ГРН
45760 ГРН
45760 ГРН
45760 ГРН
45760 ГРН
41600 ГРН
41600 ГРН
49712 ГРН
49712 ГРН
99476 ГРН
99476 ГРН
74620 ГРН
74620 ГРН
74620 ГРН
74620 ГРН
52208 ГРН
52208 ГРН
43004 ГРН
43004 ГРН
74620 ГРН
74620 ГРН
59696 ГРН
59696 ГРН
29848 ГРН
29848 ГРН
13000 ГРН
13000 ГРН
18200 ГРН
18200 ГРН
18200 ГРН
18200 ГРН
13000 ГРН
13000 ГРН
29848 ГРН
29848 ГРН
52208 ГРН
52208 ГРН
74620 ГРН
74620 ГРН
49712 ГРН
49712 ГРН
64636 ГРН
64636 ГРН
45760 ГРН
45760 ГРН
39780 ГРН
39780 ГРН
64636 ГРН
64636 ГРН
39780 ГРН
39780 ГРН
45760 ГРН
45760 ГРН
39780 ГРН
39780 ГРН
24856 ГРН
24856 ГРН
149188 ГРН
149188 ГРН
69628 ГРН
69628 ГРН
43004 ГРН
43004 ГРН
45760 ГРН
45760 ГРН
49712 ГРН
49712 ГРН
39780 ГРН
39780 ГРН
45760 ГРН
45760 ГРН
45760 ГРН
45760 ГРН
41600 ГРН
41600 ГРН
49712 ГРН
49712 ГРН
99476 ГРН
99476 ГРН
74620 ГРН
74620 ГРН
74620 ГРН
74620 ГРН
52208 ГРН
52208 ГРН
43004 ГРН
43004 ГРН
74620 ГРН
74620 ГРН
59696 ГРН
59696 ГРН
29848 ГРН
29848 ГРН
13000 ГРН
13000 ГРН
18200 ГРН
18200 ГРН
18200 ГРН
18200 ГРН
13000 ГРН
13000 ГРН
29848 ГРН
29848 ГРН
52208 ГРН
52208 ГРН
74620 ГРН
74620 ГРН
49712 ГРН
49712 ГРН
64636 ГРН
64636 ГРН
45760 ГРН
45760 ГРН
39780 ГРН
39780 ГРН
64636 ГРН
64636 ГРН
39780 ГРН
39780 ГРН
45760 ГРН
45760 ГРН
39780 ГРН
39780 ГРН
24856 ГРН
24856 ГРН
149188 ГРН
149188 ГРН
69628 ГРН
69628 ГРН
43004 ГРН
43004 ГРН
45760 ГРН
45760 ГРН
49712 ГРН
49712 ГРН
39780 ГРН
39780 ГРН
45760 ГРН
45760 ГРН
45760 ГРН
45760 ГРН
41600 ГРН
41600 ГРН
49712 ГРН
49712 ГРН
99476 ГРН
99476 ГРН
74620 ГРН
74620 ГРН
74620 ГРН
74620 ГРН
52208 ГРН
52208 ГРН
43004 ГРН
43004 ГРН
74620 ГРН
74620 ГРН
59696 ГРН
59696 ГРН
29848 ГРН
29848 ГРН
13000 ГРН
13000 ГРН
18200 ГРН
18200 ГРН
64636 ГРН
64636 ГРН
39780 ГРН
39780 ГРН
45760 ГРН
45760 ГРН
39780 ГРН
39780 ГРН
24856 ГРН
24856 ГРН
149188 ГРН
149188 ГРН
69628 ГРН
69628 ГРН
43004 ГРН
43004 ГРН
45760 ГРН
45760 ГРН
49712 ГРН
49712 ГРН
39780 ГРН
39780 ГРН
45760 ГРН
45760 ГРН
45760 ГРН
45760 ГРН
41600 ГРН
41600 ГРН
49712 ГРН
49712 ГРН
99476 ГРН
99476 ГРН
74620 ГРН
74620 ГРН
74620 ГРН
74620 ГРН
52208 ГРН
52208 ГРН
43004 ГРН
43004 ГРН
74620 ГРН
74620 ГРН
59696 ГРН
59696 ГРН
29848 ГРН
29848 ГРН
13000 ГРН
13000 ГРН
18200 ГРН
18200 ГРН
18200 ГРН
18200 ГРН
13000 ГРН
13000 ГРН
29848 ГРН
29848 ГРН
52208 ГРН
52208 ГРН
74620 ГРН
74620 ГРН
49712 ГРН
49712 ГРН
64636 ГРН
64636 ГРН
45760 ГРН
45760 ГРН
39780 ГРН
39780 ГРН
Показання та протипоказання
Позбутися жирових відкладень на стегнах, ногах і сідницях за допомогою дієт і занять спортом складно, оскільки жіночий організм має свої особливості. Естроген — це гормон, що виробляється в певний період циклу, і для його нормального синтезу потрібен жир. Саме тому дієти не дають результатів. Але можна зробити ліпосакцію стегон за допомогою лазера. Процедура триває недовго — за годину можна позбутися жиру й повернути красу фігури.
Показання
прямих показань до ліпосакції немає.
Протипоказання
цукровий діабет;
погана згортальність крові;
гострі інфекційні процеси;
загострення хронічних хвороб;
вагітність і годування грудьми.
Як проходить операція:
Покроковий опис процедури та основні етапи ліпосакції стегон
-
Ліпосакція стегон: підготовка 1
Ліпосакція внутрішньої та зовнішньої частин стегон, ніг і сідниць є малотравматичною операцією, проте потребує ретельної підготовки, щоб результат відповідав очікуванням і не виникла потреба в додатковому відновленні організму. Перед процедурою необхідно здати загальні аналізи для оцінки стану здоров’я, пройти коагулограму для перевірки згортання крові та зробити ЕКГ, щоб оцінити роботу серця. У клініці можна пройти всі підготовчі обстеження, здати аналізи та, за потреби, отримати консультації вузькопрофільних спеціалістів.
-

Ліпосакція стегон: проведення операції 2
Щоб прибрати жир із внутрішньої та зовнішньої сторони стегон, ліпосакцію проводять у кілька послідовних етапів. Спочатку у клініці фотографують зону, яка підлягає корекції, щоб у майбутньому можна було оцінити результат. Процедура виконується під місцевою анестезією. Хірург робить 1–3 невеликих проколи діаметром 3–5 мм, враховуючи розташування жирових відкладень. Далі жир розріджують за допомогою лазера, після чого розм’якшені відкладення видаляють. По завершенні операції проколи зашивають косметичними швами та накладають стерильну пов’язку. За один сеанс можна видалити до 5 літрів жиру, а якщо обсяг більший — проводять ще одну або кілька процедур. У разі потреби корекції інших зон ліпосакцію виконують із перервами, щоб організм встиг відновитися.
-

Ліпосакція стегон: реабілітація 3
Реабілітаційний період після ліпосакції стегон триває близько місяця, і в цей час важливо дотримуватися певних правил. Потрібно обмежити фізичні навантаження та виключити заняття спортом, носити компресійну білизну протягом усього періоду відновлення, дотримуватися збалансованого харчування, відмовитися від шкідливих звичок і пити достатню кількість чистої води. У разі потреби, при виникненні небажаних реакцій або питань, завжди можна звернутися на прийом до наших лікарів у Черкасах. Ліпосакція стегон — це хірургічне втручання, яке впливає на організм, проте при дотриманні всіх рекомендацій відновлення проходить легко та швидко.
Чому обирають медичний центр "Авіцена"
-
Професіоналізм
У нашій клініці працюють досвідчені фахівці, які постійно вдосконалюють свої навички та забезпечують точну діагностику й безпечне лікування.
-
Сучасні технології
Клініка використовує новітнє обладнання, сучасні технології та інноваційні підходи, що відповідають міжнародним стандартам медицини і забезпечують якісну допомогу в усіх спеціальностях.
-
Максимальна стерильність
Максимальна стерильність. Замкнений цикл стерилізації, індивідуальне пакування інструментів, регулярний бактеріологічний контроль.

Виникли питання? Телефонуйте
098 469 85 78
